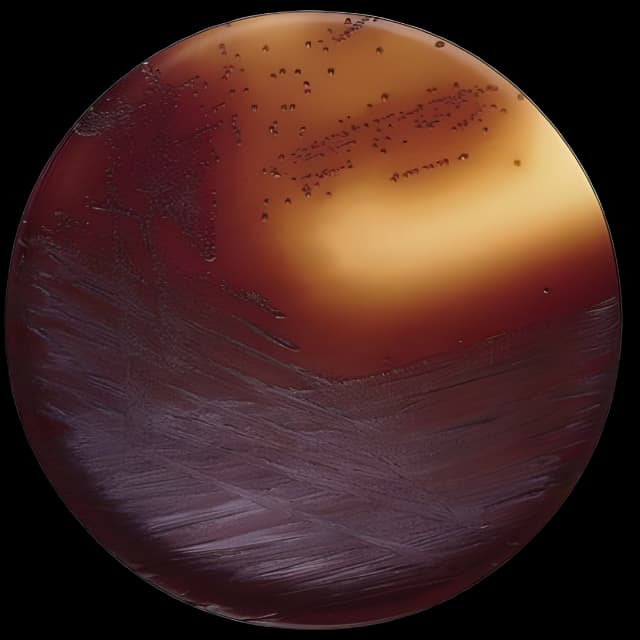
Dehydrated Culture Media BD Difco™ Baird-Parker Agar Base Dehydrated

Dehydrated Culture Media BD Difco™ Baird-Parker Agar Base Dehydrated
USAMP#32307844SKU: DF0768173BD Difco™

Product Spotlight
- Manufacturer: BD 276840
- Formulation: Pancreatic digest of Casein 10g/L, Beef extract 5g/L, Yeast extract 1g/L, Glycine 12g/L, Sodium Pyruvate 10g/L, Lithium Chloride 5g/L, Agar 20g/L